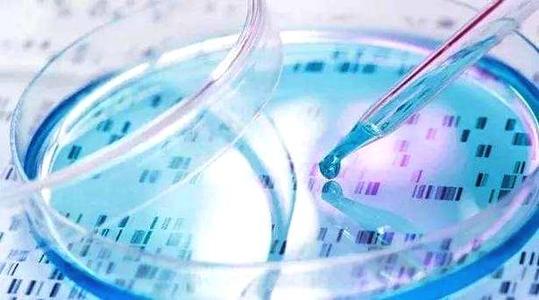
做淮南助孕试管婴儿提高成功率的6个技巧

-

安徽淮南试管婴儿医院排名?哪家医院试管成功率高?
安徽淮南试管婴儿医院排名?哪家医院试管成功率高?截至目前,安徽省共有10家医疗机构获得了开展辅助生殖技术的资质。大部分试管婴儿医院集中在合肥、亳州、芜湖等城市,省..
2023-08-18 10:59 -
2023淮南有申请供卵做第三代试管婴儿的正规医院吗?
淮南现有的淮南新华医院、淮南新华医疗集团北方医院、淮南市东方集团广济医院、淮南东方医院集团谢一医院、淮南东方医院、淮南市妇幼保健院等医院都没有可开展试管婴儿辅助..
2024-03-12 09:19 -

安徽淮南第三代试管婴儿医院排名?哪家医院试管胚胎移植成功率高?
安徽淮南排名?哪家医院试管胚胎移植成功率高?截至目前,安徽省共有10家医疗机构获得了开展辅助生殖技术的资质。大部分试管婴儿医院集中在合肥、亳州、芜湖等城市,省内一..
2024-07-15 09:12 -

备孕2年没怀孕,淮南有没有做试管婴儿的医院?
题主备孕2年都没有怀孕不知道有没有去医院检查过,如果要做试管婴儿的话就要趁早,但需要知道的是淮南没有能做试管的医院,所以有这样的需求最好去大一点的城市,选择正规..
2024-11-07 09:34 -

备孕2年没怀孕,淮南有没有做助孕试管婴儿的医院?
题主备孕2年都没有怀孕不知道有没有去医院检查过,如果要做试管婴儿的话就要趁早,但需要知道的是淮南没有能做试管的医院,所以有这样的需求最好去大一点的城市,选择正规..
2025-04-25 09:18 -

大龄做淮南助孕试管婴儿风险大吗
大龄做淮南助孕试管婴儿风险大吗?生活中,不管做什么事情其实都是有一定的风险的,比如投资,比如做生意等等,还有看病的时候比如需要做手术等等,都是存在一定成功和失败..
2025-05-27 09:03 -

做淮南助孕试管婴儿攻略都是怎么来的
做淮南助孕试管婴儿攻略都是怎么来的?现在人们生活品质高了,一年一两次的旅游是很多人都已经可以实现的了,那么在旅游前大家会做有些攻略,这样可以帮助自己准备好自己想..
2025-05-27 09:25 -

染色体异常有做淮南助孕试管婴儿的成功案例吗
淮南助孕试管婴儿前期的流程重要吗?近几年,不孕不育人群在不断的增多,好在大家是生活在科技很发达的现在,很多不孕不育家庭可以通过人工受精技术生育,完成生育梦的,在..
2025-05-27 09:42 -

甲状腺可以考虑淮南助孕试管婴儿吗
甲状腺可以考虑淮南助孕试管婴儿吗?甲状腺是一种很常见的疾病,这种疾病治疗缓慢,对生育有很大的影响,所以如果想要怀孕一定要抓紧机会才可有,近几年针对怀孕难的家庭,..
2025-05-27 09:52 -

淮南助孕试管婴儿前期的流程重要吗
淮南助孕试管婴儿前期的流程重要吗?近几年,不孕不育人群在不断的增多,好在大家是生活在科技很发达的现在,很多不孕不育家庭可以通过人工受精技术生育,完成生育梦的,在..
2025-05-27 10:02 -
做淮南助孕试管婴儿提高成功率的6个技巧
做淮南助孕试管婴儿技术,虽然成功率很高,可以做到优生优育,但是在试管人群中依然有人成功,有人也会失败的,所以在试管前要提前做些事情帮助自己提高一次成功的几率,今..
2025-05-27 10:08 -

做淮南助孕试管婴儿怎么省钱更合理
做淮南助孕试管婴儿怎么省钱更合理?现在的谁会赚钱是真的不容易,所以在平时既不能铺张浪费,但是该花的还是得花,所以如果能省钱也是不错的,在国内,有很多赴泰生子的家..
2025-05-27 10:18 -

淮南助孕试管婴儿宝宝健康有保证没
淮南助孕试管婴儿宝宝健康有保证没?在不孕不育发病率很高的现在,辅助生育技术真的很重要,近几年,随着试管技术的不断发展,帮助了不少家庭实现了怀孕梦,但是因为是人工..
2025-05-27 10:22 -

输卵管堵塞做淮南助孕试管婴儿多少钱
输卵管堵塞做淮南助孕试管婴儿多少钱?输卵管堵塞是近几年造成女性不孕的常见疾病,大家都知道,输卵管是是送精卵相遇的桥梁,如果一旦堵塞,精卵无法相遇,自然就不会产品..
2025-05-28 09:28
微信分享
扫描二维码分享到微信或朋友圈